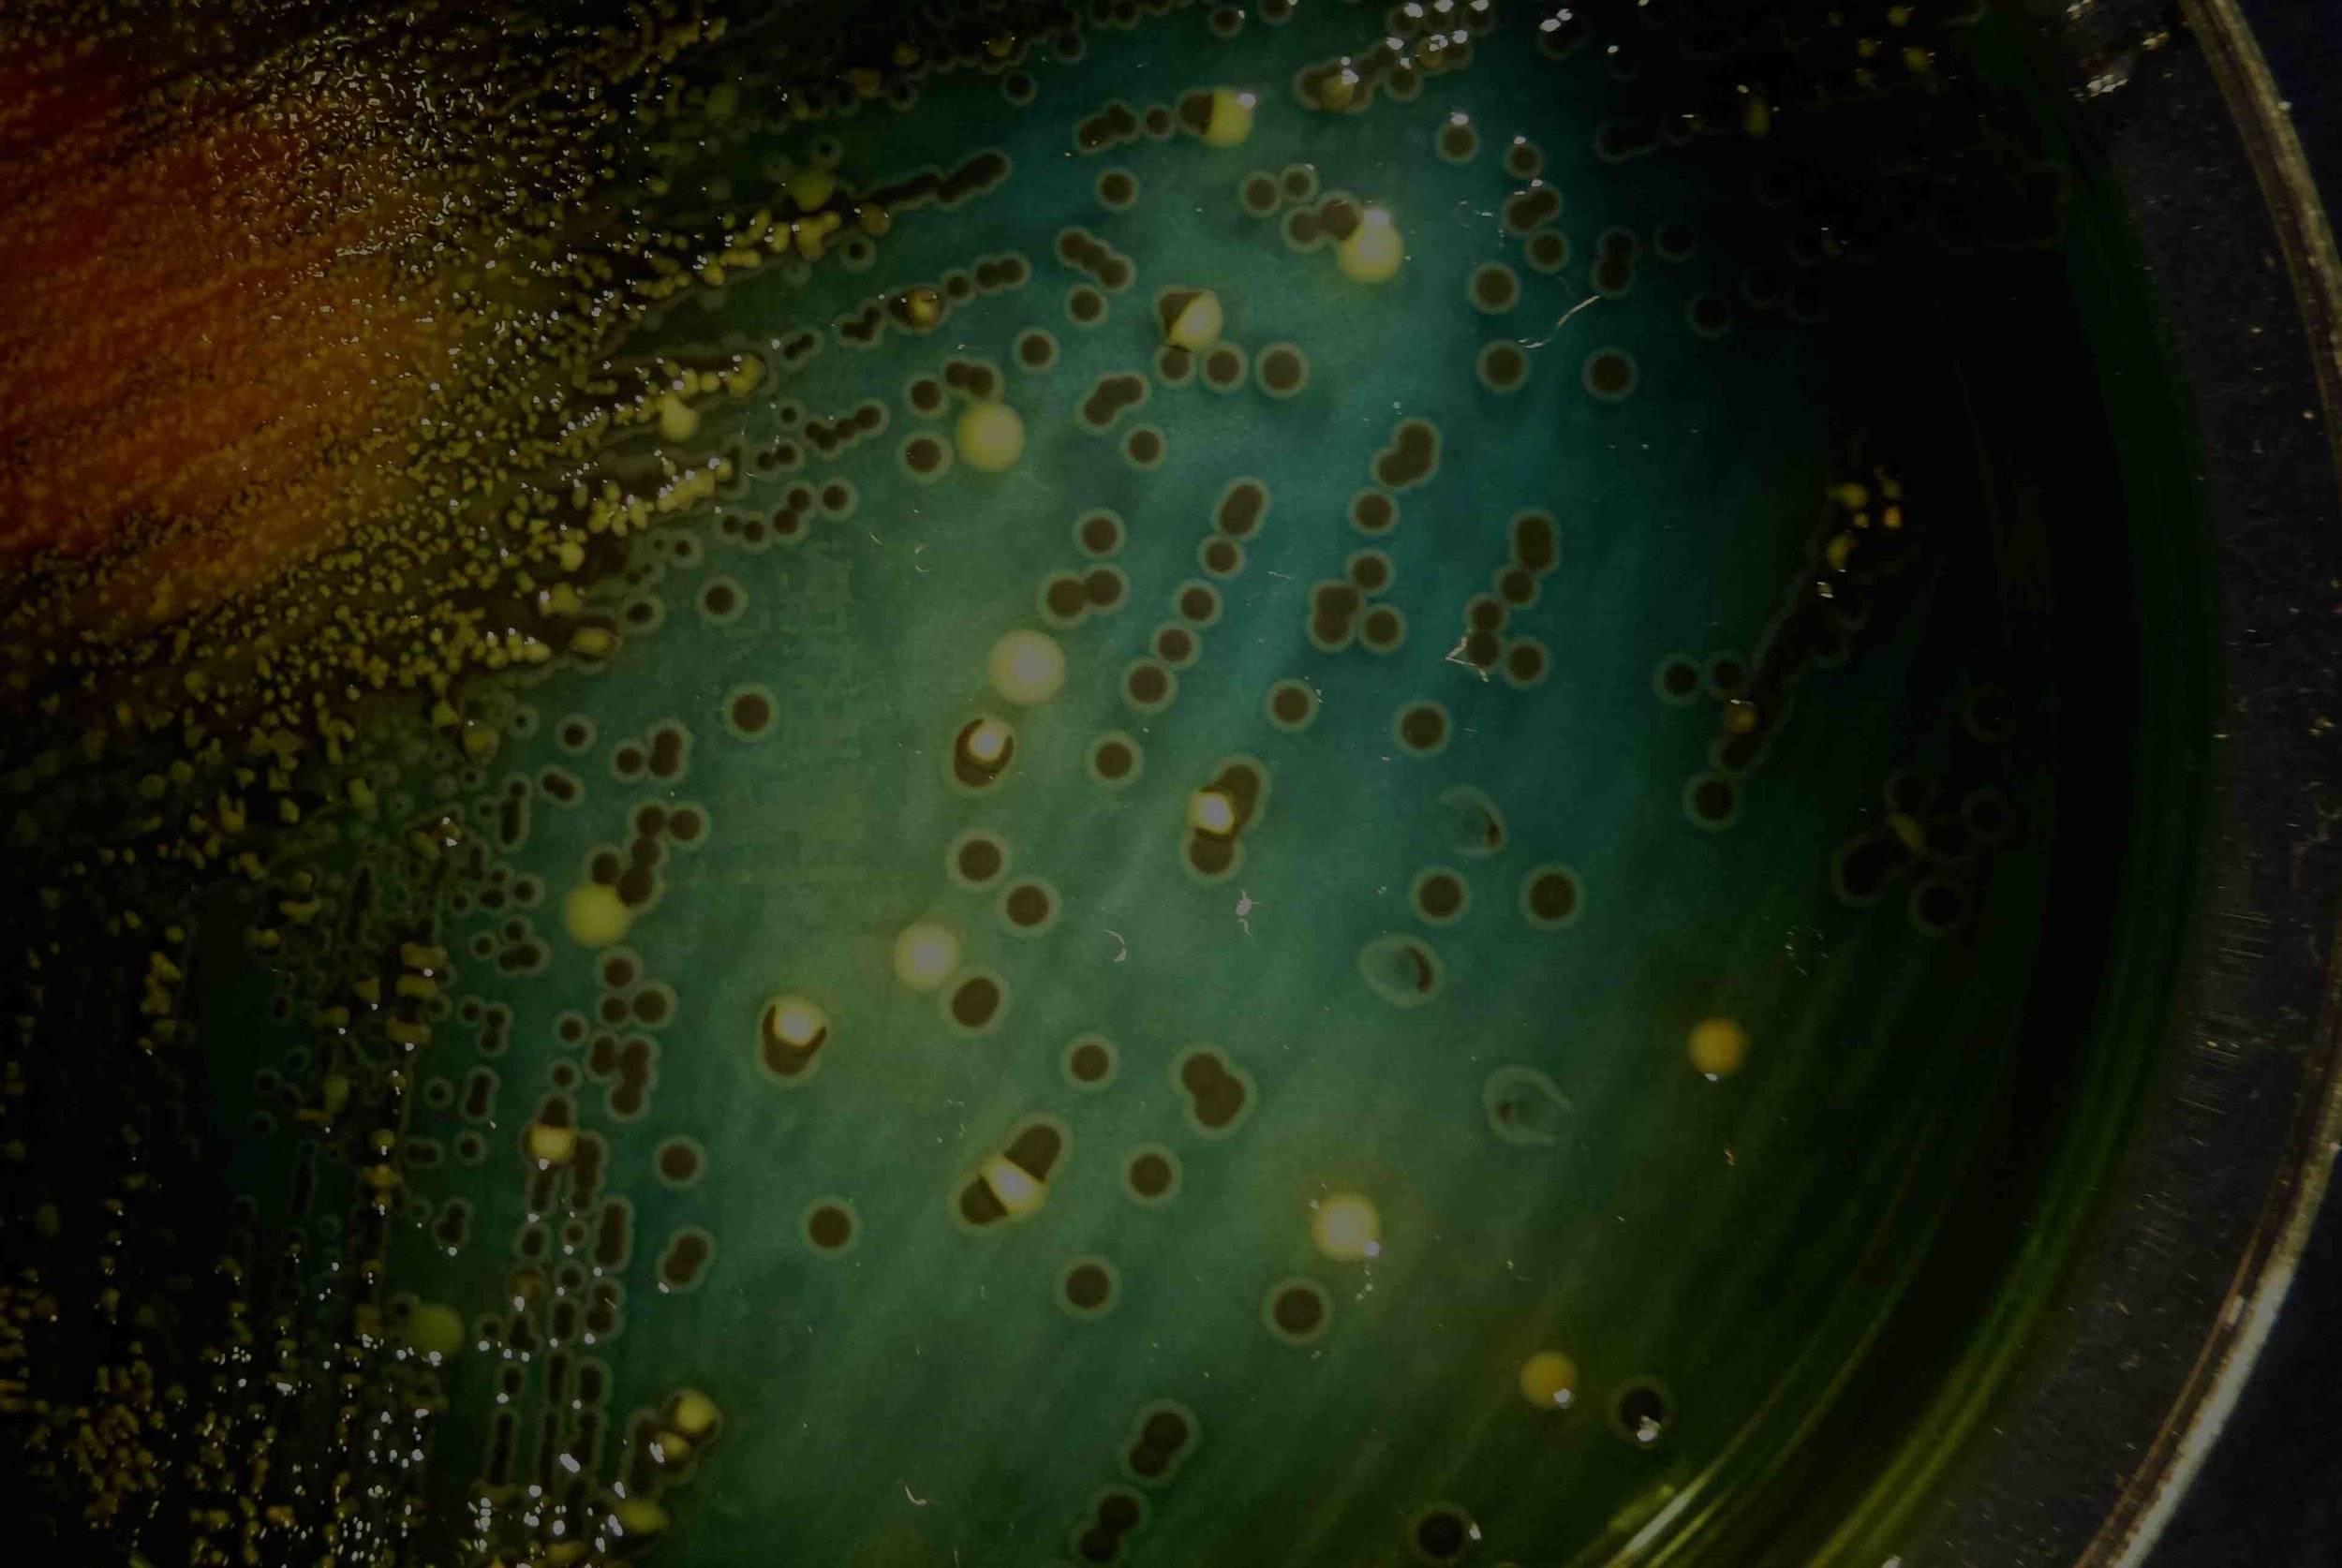
Bacille de la typhoïde : colonies sur gélose.

Ne fais pas ta Marie Typhoïde !
Quand j’ai ouvert le labo en 1989, des témoignages d’anciens m’avaient surpris : la fièvre typhoïde n’était pas une maladie rare dans nos campagnes. Et je pouvais juger de visu certaines redoutables séquelles de cette maladie ! Moi qui étais en quelque sorte un néo rural, mon approche un peu naïve de la nature était remise en cause.
Car cette maladie provenait très souvent de l’eau des puits en usage avant l’organisation du système de distribution d’eau.
La vérité qui sort du fond du puits, l’eau cristalline, pure et rafraichissante, extraite des entrailles de notre bonne vieille terre, loin des miasmes de la vie urbaine. En été, quelle agréable fraîcheur se dégageait de cette profondeur, nos têtes enfantines penchées sur ses margelles…
Telles étaient les images bucoliques que je colportais sans doute, en toute ignorance, en toute illusion. Car le mensonge, la maladie pouvait tout aussi bien jaillir de cette apparente clarté !
Tout au long de notre histoire, les sociétés d’hommes se sont sédentarisées près des points d’eau, quoi de plus évident, ça coule de source.
Pas de vie sans eau.
Plus tard, le sourcier sollicité a indiqué l’endroit où forer. Les fontaines étaient des lieux respectés, voire des lieux Saints ; certaines même étaient parées de vertus thérapeutiques. Et les plus fameuses faisaient l’objet de pèlerinages.
Cette sédentarisation, apparue progressivement il y a 10 000 ans, a été rendue possible grâce à l’élevage et à l’agriculture. Elle s’est accompagnée du traitement des déchets, plus nombreux par définition. Car quand le chasseur cueilleur parsème son espace naturel de crottes et d’urines, le traitement biologique de ces excreta est aussi rapide qu’efficace : quelques insectes coprophages, qui se délectent donc de l’excrémentiel, puis une cohorte de bactéries recyclantes opèrent de concert. En quelques heures, si la température est clémente, la place est nette.
Mais quand l ‘homme s’est immobilisé, organiser la propreté fut une toute autre affaire. Il y eut des villes propres, comme des immondes, des civilisations raffinées, comme d’autres martyrisées par le fécal. Dans notre pays, l’excrément humain a souvent été mal traité, ignoré, caché, voir tabou. Dans les civilisations chinoise et japonaise, l’étron a toujours été considéré comme un engrais précieux, et objet de commerce même, au Japon, entre autres.
Chez nous, dans nos campagnes, la selle a longtemps juste été posée à quelques mètres de la maison. Elle-même construite à quelques mètres du puits. Il n’en fallait pas plus à la pluie d’orage, au ruissellement pour faire le joint, à travers les fissures. La boucle était bouclée, pour l’agent de la typhoïde, qui ne s’attaque qu’à l’homme, mais qui peut résister quelques mois en extérieur.
La typhoïde a disparu de nos pays, avec l’arrivée de l’eau courante et les procédés modernes de stérilisation. Au début du XX ième siècle, c’est une toute autre histoire.
En 1900, une jeune américaine Mary Mallon, qui vient d’émigrer d’Irlande, commence sa carrière de cuisinière, embauchée dans des familles bourgeoises de l’époque, à New York et sa région. Elle porte la guigne : partout où elle passe, elle sème la maladie, comme d’autres la bonne humeur. Elle n’imagine pas un instant en être à l’origine. Elle constate que ce pays d’accueil est bien plus victime de petites épidémies que son Irlande natale.
Après plusieurs années de service, elle est embauchée chez une riche personne, vivant dans un quartier cossu, où les cas sont plutôt rares. A la suite d’une typhoïde ayant touché sa famille, son patron décide de contacter un épidémiologiste. Sur les repas possiblement contaminants seul un dessert glacé a échappé à la cuisson par nature stérilisante. Il enquête sur la glace, ce qui ne donne rien. La notion de porteur sain est connu à l’époque par ces spécialistes, même si les preuves n’existent pas. Sur une cinquantaine de malades recensés par le spécialiste cinq en sont morts dans les différentes familles. Sans doute la partie émergée de l’iceberg.
Le médecin demande à Marie de faire des analyses de selles, ce qu’elle refuse, ne se sentant nullement malade.
C’est sous contrainte donc que les médecins arrivent à leur fin, ce qui est illégal à l’époque. Les analyses concordent toutes : Marie excrète en permanence Salmonelle typhi
C’est la première personne reconnue au monde entier comme porteuse d’une bactérie pathogène, mais n’en souffrant d’aucune manière.
Les mains sales font le reste, c’est à dire une cuisine douteuse. Ils lui demandent alors d’arrêter son travail. Ou de se faire enlever la vésicule biliaire. Mais elle résiste à leur injonction, elle ne comprend pas pourquoi, n’étant pas malade, elle rendrait malades les autres. Elle se sent profondément martyrisée.
Elle reprend son travail, et contamine ainsi de nouvelles personnes. Excédés, les médecins la mettent en quarantaine pour trois ans, puis la libèrent de nouveau en ayant sa parole de « faire attention », ce qu’elle ne fait pas. Il aurait simplement fallu qu’elle se lave les mains très fréquemment, surtout après le passage aux toilettes, bien sûr.
Elle change de nom, mais finit encore par se faire repérer.
Les autorités sanitaires la remettent alors « définitivement « en quarantaine » sur l’île de North Brother Island, dans une clinique initialement installée pour y recevoir les victimes de la variole. Elle travaille dans le laboratoire, et sa réputation est faite à travers le pays ; les journalistes qui l’interviewent sont invités de ne pas même recevoir un verre d’eau de sa part. Elle subit alors la plus longue quarantaine de l’histoire.
A sa mort, elle est autopsiée, et les biologistes mettent en évidence la bactérie de la fièvre typhoïde dans sa vésicule biliaire. On a montré depuis que 2 % d’une population contaminée pouvait devenir porteuse chronique, la présence de calculs biliaires favorisant ce portage.
La grande guerre de 1914 voit le triomphe de l’eau de Javel, 1 gramme dans 1 M3 mettait les poilus à l’abri de ces mortelles épidémies de guerre, le microbe tuant souvent plus que l’arme. Un siècle plus tard, on manie le Chlore avec précaution, cette molécule étant hyper réactive.
On sait depuis aménager et entretenir des puits où tout risque est exclu.
Il reste une expression anglaise « don’t be a Typhoïd Mary » l’image d’une personne qui, malgré elle, amène une poisse partout où elle passe, sème des choses négatives, la maladie. Un langage en quelque sorte modernisé, vrai, qui succède « au mauvais oeil », à la « scoumoune », à la « malédiction » mots variés de l’antique superstition.
Le péril fécal n’en est pas écarté pour autant dans nos régions, il s’est déplacé vers les zones à grande densité d’élevages, où la gestion d’énormes quantités d’excréments ne peut être laissée au hasard. Si les biologistes ont perdu la Salmonelle de la typhoïde dans nos pays, ils ont gagné la Salmonelle des élevages de poulet peu après, bien moins féroce, mais qui peut quand même tuer un bébé ou un vieillard.